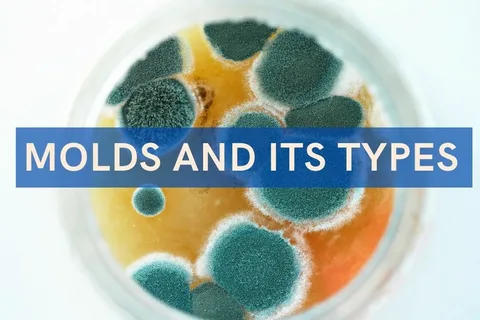

Introduction
Have you ever walked into a room and noticed a strange, damp odor that just didn’t feel right? Maybe it reminded you of old books, wet socks, or even something earthy. If so, you might have encountered mold without even seeing it.
Understanding what mold smells like is more important than most people realize. That musty scent is often the first warning sign that something is growing where it shouldn’t be. Think of it as your home’s way of whispering, “Hey, something’s not right here.”what does mold smell like
In this guide, we’ll break down everything you need to know—what mold smells like, why it smells that way, and how to deal with it before it becomes a bigger problem.
1. What Is Mold and Why Does It Smell?

Mold is a living fungus that flourishes in moist, warm conditions, spreading by releasing microscopic spores that drift through the air and settle onto nearby surfaces.
As mold develops and spreads, it emits microscopic gases known as microbial volatile organic compounds (MVOCs).. These are tiny gases that create that signature odor. In simple terms, mold “breathes out” smells as it feeds and grows.
2. The Typical Smell of Mold
So, what does mold smell like exactly?
Most people describe it as:
-
Musty
-
Damp
-
Earthy
-
Stale
Imagine opening a long-forgotten basement or flipping through an old, dusty book—that’s the kind of smell we’re talking about.
Analogy: Think of mold smell like a wet towel left in a corner for days. It’s not just unpleasant—it signals neglect and moisture.
3. Different Types of Mold Odors
Not all mold smells the same. The scent can vary depending on the type and location.
Not all mold smells the same. The scent can vary depending on the type and location.
Earthy Smell
Often found in basements or soil-exposed areas.
Rotting Smell
More intense and unpleasant, sometimes similar to decaying food.
Sweet or Chemical-Like Smell
Certain molds give off a slightly sweet but strange odor.
Sour Smell
Common in areas with trapped moisture, like under sinks.
Each type gives you a clue about what might be happening behind the scenes.
4. Why Mold Produces That Musty Smell
The musty odor isn’t random—it’s a byproduct of mold’s life cycle.
As mold feeds on materials like wood, fabric, or drywall, it breaks them down. During this process, it releases gases that we detect as smell.
Key Point:
The stronger the smell, the more active the mold growth might be.
5. Common Places You Might Notice Mold Smell
Mold loves moisture, so you’ll usually find it in damp areas.
Bathrooms
-
Behind tiles
-
Around sinks and tubs
Basements
-
Poor ventilation makes them ideal breeding grounds
Kitchens
-
Under sinks or behind appliances
Closets
-
Especially if they’re dark and rarely opened
Air Conditioning Units
-
Moisture buildup can cause hidden mold
If you smell something odd in these places, it’s worth investigating.
6. Mold Smell vs Other Household Odors
It’s easy to confuse mold smell with other odors.
Mold vs Mildew
-
Both smell musty, but mildew is usually lighter and less intense
Mold vs Pet Odor
-
Pet smells are sharper and more distinct
Mold vs Food Rot
-
Rotting food smells stronger and more immediate
Tip: Mold smell tends to linger and doesn’t go away easily, even after cleaning.
7. Can Mold Smell Be Harmful?
The smell itself isn’t the real danger—it’s what’s causing it.
Exposure to mold can lead to:
-
Allergies
-
Sneezing and coughing
-
Headaches
-
Breathing issues
If you notice symptoms along with the smell, it’s a sign you shouldn’t ignore.
8. How to Confirm If the Smell Is Mold
Not sure if it’s mold? Here are a few ways to check:
Visual Inspection
Look for:
-
Black, green, or white spots
-
Discoloration on walls or ceilings
Follow the Smell
Track where it’s strongest—that’s usually the source.
Check Moisture Levels
Use a moisture meter if possible.
Professional Testing
Experts can confirm mold presence with accuracy.
9. What Causes Mold to Grow Indoors
Mold doesn’t just appear—it needs certain conditions.
Moisture
Leaks, spills, or humidity
Poor Ventilation
Air that doesn’t circulate traps moisture
Warm Temperatures
Mold thrives in warmth
Organic Materials
Wood, paper, and fabric provide food
Remove one of these factors, and you reduce the risk significantly.
10. How to Get Rid of Mold Smell
Getting rid of the smell means eliminating the source.
Clean the Affected Area
Use vinegar or baking soda solutions
Improve Ventilation
Open windows or use fans
Use Dehumidifiers
Reduce moisture in the air
Replace Damaged Materials
Sometimes, cleaning isn’t enough
Important: Masking the smell with air fresheners won’t solve the problem.
11. Preventing Mold Odors in the Future
Prevention is always better than cure.
Keep Areas Dry
Wipe down wet surfaces quickly
Fix Leaks Immediately
Don’t let water sit
Use Exhaust Fans
Especially in bathrooms and kitchens
Regular Cleaning
Dust and vacuum frequently
Small habits can make a big difference.
12. When to Call a Professional
Sometimes, mold problems go beyond DIY solutions.
Call an expert if:
-
The smell is very strong
-
Mold covers a large area
-
You have health symptoms
-
The source is hidden (like inside walls)
Professionals have tools and expertise to handle it safely.
13. Conclusion
Mold smell is more than just an unpleasant odor—it’s a warning sign you shouldn’t ignore. That musty, damp scent is your home’s way of telling you something is off.
By understanding what mold smells like and where it hides, you can take action early. Whether it’s a small patch in the bathroom or a hidden issue behind walls, catching it early can save you time, money, and stress.
Remember, your nose is often your first line of defense—trust it.
14. FAQs
1. What is the first sign of mold smell?
The first sign is usually a musty, damp odor that doesn’t go away even after cleaning or airing out the space.
2. Can mold smell come and go?
Yes, it can. Changes in humidity and temperature can make the smell stronger or weaker at different times.
3. Is mold smell always visible?
No, mold can grow behind walls, under floors, or inside vents, making it hidden but still noticeable by smell.
4. How long does it take for mold smell to appear?
Mold can start producing odors within 24–48 hours in damp conditions.
5. Can you get rid of mold smell without removing mold?
No, the smell will return unless the source of the mold is completely removed.


